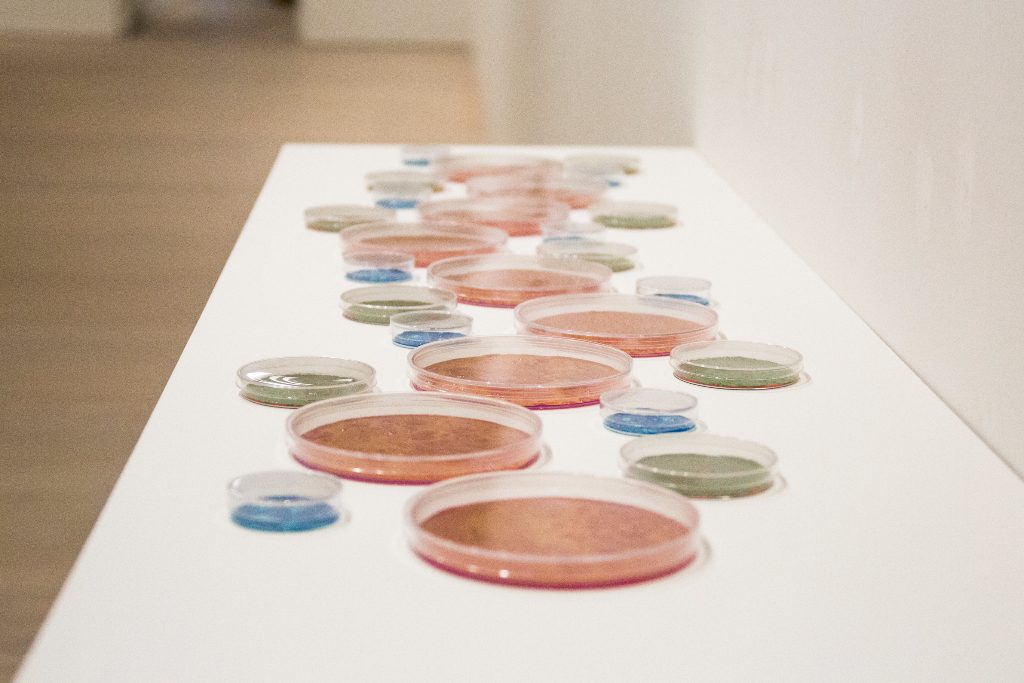

Aisha Cahn: Embrace at Saatchi Gallery
Embrace is the innovative new exhibition at the Saatchi Gallery from British artist Aisha Cahn, presented in collaboration with The Royal Free Charities.
Cahn’s work aims to bring together the disciplines of faith and science through the form of conceptual art, drawing on her Indian origin, Islamic faith and British nationality to connect the Eastern and Western hemispheres. In this exhibition, the contemporary works displayed take from Cahn’s personal experience of her mother’s struggle with cancer and the scientific study of cells. The accompanying text highlights how her mother’s strength, words and desire to “embrace” her final moments of life inspired her: “Death is a certainty, life isn’t, therefore one should embrace it and not fear it.” It was also through a study of the progress in drug development and immunology at places like Imperial College, Cancer Research UK, and the Royal Free Hospital that Cahn was able to develop the distinctive style and colouring of the pieces, with the breakthrough discovery that T cells and NK cells can destroy cancer being the initial trigger for her series.
The unique combination of art and science, a common theme in Cahn’s work, results in an interesting array of paintings, as well as two installations, technical drawings and silkscreen prints. The use of bright colours reflects a sense of positivity, which emphasise the approach Cahn’s mother and she took toward the terminal prognosis together despite the devastating reality of it.
In one collection of pieces, images of cell structures sit against mood boards of coloured blocks. A stand-out set of prints take the outline of cells in contrasting colours to create striking artworks. In other abstract compositions, a stunning range of layered, blurred and mixed colours from bright red, to deep purple and blue, pale blue, yellow and pink, replicate an image of flowing cells under a microscope, with a texturised technique adding to the effect, the scientific subject of the pieces contrasting with the evocative end result of their expanse and hue. A selection of 27 petri dishes filled with bubbled burnt orange, dark blue and olive green paint stand out scattered across a white surface while a stunning installation sees delicate glowing teal orbs hung by near-invisible wire from the ceiling.
Embrace presents a fascinating and evocative way of exploring both science and emotion in single artworks, finding a euphoria and vibrancy despite the destructive disease at the centre. It is perhaps only the conceptual nature of the exhibition that leaves little to really get your teeth into.
Sarah Bradbury
Photos: Erol Birsen
Aisha Cahn: Embrace is at the Saatchi Gallery from 15th until 22nd March 2017, for further information visit here.
For further information about Aisha Cahn visit here.






























Facebook
Twitter
Instagram
YouTube
RSS